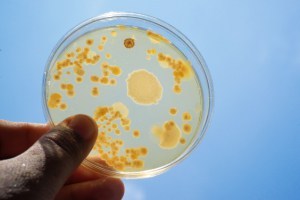

Platypus Technologies continues their dedication to helping customers perfect their processes with their latest guide entitled ‘Top 5 Reasons Why a Cell Assay Might Fail’. Read more on their website.

Platypus Technologies continues their dedication to helping customers perfect their processes with their latest guide entitled ‘Top 5 Reasons Why a Cell Assay Might Fail’. Read more on their website.